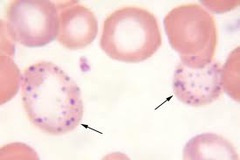
Basophilic stippling

Hematology Exam 3
0.0(0)
Card Sorting
1/144
Earn XP
Description and Tags
Last updated 2:25 PM on 9/28/22
Name | Mastery | Learn | Test | Matching | Spaced | Call with Kai |
|---|
No analytics yet
Send a link to your students to track their progress
145 Terms
1
New cards
What RBC inclusion is composed of DNA and seen in post-splenectomy, megaloblastic anemias, or hemolytic anemias?
Howell-Jolly body

2
New cards
What RBC inclusion is composed of RNA and is associated with decreased RBC survival & erythroid hyperplastic marrow?
Reticulocyte/polychromasia

3
New cards
What RBC inclusion is composed of iron and is seen in sideroblastic anemia or thalassemia?
Pappenheimer body

4
New cards
What RBC inclusion is composed of precipitated hemoglobin and seen in G6PD deficiency using supravital stain?
Heinz body

5
New cards
What RBC inclusion is crystalized hemoglobin C and seen in Hemoglobin C disease?
C crystal

6
New cards
What is a ringed sideroblast composed of?
Iron

7
New cards
What RBC inclusion is composed of RNA aggregates and is seen in thalassemia or lead poisoning?
Basophilic stippling
8
New cards
What is a nucleated red blood cell composed of?
DNA

9
New cards
What is the formula for calculating hematocrit?
RBC x MCV/10
10
New cards
What affects the MCV?
Agglutination
11
New cards
Will an increased WBC count affect the RBC count?
Yes
12
New cards
Does lipemia affect the hemoglobin or hematocrit?
Hemoglobin
13
New cards
What is the formula for calculating the MCV?
Hct x 10/RBC
14
New cards
What is the formula for calculating the MCH?
Hgb x 10/RBC
15
New cards
What is the formula for calculating the MCHC?
Hgb x 100/Hct
16
New cards
What is the reference range for MCV?
80-100 fL
17
New cards
What is the reference range for MCH?
28-32 pg
18
New cards
What is the reference range for MCHC?
32-36% g/dl
19
New cards
What is the reference range for RDW?
11.5-14.5%
20
New cards
What is a macrocytic anemia we learned about?
Megaloblastic anemia
21
New cards
What is defective in megaloblastic anemia?
Defective DNA synthesis from B12 or folate; poor diet
22
New cards
What will the bone marrow show in megaloblastic anemia?
Asynchrony, karryohexis, giant metamyelocytes, & bands
23
New cards
What are the laboratory results for megaloblastic anemia?
Hypersegmented neutrophils, increased DBili, Bili, and LD, decreased retic, pancytopenia
24
New cards
How is megaloblastic anemia treated?
Vitamin therapy
25
New cards
What tapeworm is associated with megaloblastic anemia?
Diphyllobothrium latum
26
New cards
What are causes of folate deficient?
Alcoholism, poverty, pregnancy,
27
New cards
What do you lack in pernicious anemia?
Intrinsic factor
28
New cards
What is the function of intrinsic factor?
Aids in B12 absorption
29
New cards
What test confirms pernicious anemia?
Schilling test
30
New cards
What are macrocytic cells associated with other than megaloblastic anemia?
Liver disease, alcoholism, reticulocytosis,
31
New cards
What are causes of iron deficiency anemia?
Chronic blood loss, poor diet, malabsorption,
32
New cards
What are the laboratory results for iron deficiency anemia?
Decreased Fe, Ferritin, increased TIBC, increased retic only after therapy
33
New cards
What are the laboratory findings for anemia of chronic disease?
Decreased iron, TIBC, increased ferritin
34
New cards
What is the sequence of development in IDA?
1. Stores depleted
2. Iron deficient erythropoiesis
3. Hgb/hct depletion
4. Symptoms appear
2. Iron deficient erythropoiesis
3. Hgb/hct depletion
4. Symptoms appear
35
New cards
What is the treatment for IDA?
Treat underlying cause, iron supplements (based on severity: oral, transfusion, injection)
36
New cards
What is hemosiderosis?
Increased iron in reticuloendothelial cells
37
New cards
What is hemochromatosis?
More severe than hemosiderosis, excess iron is stored in the liver
38
New cards
What is the treatment for hemochromatosis?
Phlebotomy or chelation therapy to deplete iron stores
39
New cards
What are some microcytic anemias?
Iron deficiency anemia, hemochromatosis, hemosiderosis thalassemia, anemia of chronic disease, lead poisoning, sideroblastic anemia
40
New cards
What RBC inclusion is seen in lead poisoning?
Coarse basophilic stippling
41
New cards
What happens in lead poisoning?
Lead blocks heme production at several spots resulting in low heme production and low hemoglobin
42
New cards
What is defective in sideroblastic anemia?
Abnormal heme metabolism is present
43
New cards
What is defective in beta thalassemia?
Beta chains are reduced or absent, alpha chains are increased
44
New cards
What is the most common descent for beta thalassemia?
Mediterranean, South East Asians, and African American
45
New cards
What are the laboratory results for beta thalassemia?
Target cells, basophilic stippling, increased A2 & F in hemoglobin electrophoresis
46
New cards
What is a 4 gene deletion called in alpha thalassemia?
Hydrops fetalis (alpha thalassemia major)
47
New cards
What is a 3 gene deletion in alpha thalassemia?
Hgb H (4 beta chains)
48
New cards
What is a 2 gene deletion in alpha thalassemia?
Alpha thalassemia minor
49
New cards
What is a single gene deletion in alpha thalassemia?
Silent carrier
50
New cards
What hemoglobins are decreased in alpha thalassemia?
Hgb A, A2, & F
51
New cards
What is it called to have 4 gamma chains present?
Hgb Barts
52
New cards
What are the laboratory results for alpha thalassemia?
Target cells, basophilic stippling
53
New cards
What is the most common hemolytic anemia?
Malaria
54
New cards
What is defective in hereditary spherocytosis?
Inherited defect in spectrin
55
New cards
What are the laboratory results for hereditary spherocytosis?
Spherocytes, polychromasia, increased LD and Bili, increased osmotic fragility with hemolysis starting at 0.65%
56
New cards
Where does hemolysis start in a normal osmotic fragility?
0.45%
57
New cards
What is paroxysmal nocturnal hemoglbinuria?
Clonal stem cell disorder with cells sensitive to complement lysis
58
New cards
What are the laboratory results for PNH?
Red urine, + urine hemosiderin, + sucrose, + Ham's test
59
New cards
What is the older screening test for PNH?
Sugar water test
60
New cards
What is the older confirmatory test for Paroxysmal Nocturnal Hemoglobinuria
Ham's test
61
New cards
What test distinguishes hereditary spherocytosis from warm autoimmune hemolytic anemia?
DAT
62
New cards
What are the elements that must be present for hemolysis to occur in the positive tube of the Ham's test?
Acid, complement, patient RBC lacking the DAF and HRF Proteins
63
New cards
What is the current, most accurate testing methodology for PNH?
Flow cytometry with CD55 & 59
64
New cards
What happens when taking oxidant drugs with G6PD deficiency?
Oxidant drugs cause hemoglobin to denature and precipitate
65
New cards
What are the laboratory results for G6PD deficiency?
Heinz Bodies seen with supravital stain, polychromasia, increased retic, anisocytosis
66
New cards
Why must G6PD testing be done after the hemolytic crisis has passed?
During hemolytic crisis the BM is producing new cells at an accelerated rate. Retics have more of the enzyme than mature cells
67
New cards
What is seen on a peripheral smear in warm autoimmune hemolytic anemia?
Spherocytes & polychromasia
68
New cards
Which anemia occurs after an infection with infectious mono or mycoplasma?
Cold autoimmune hemolytic anemia
69
New cards
What is seen on a peripheral smear in cold autoimmune hemolytic anemia?
Agglutination
70
New cards
What happens in pyruvate kinase deficiency?
Reduced ATP production results in alterations of the RBC membrane leading to cell dehydration (echinocytes)
71
New cards
What is the defect in sickle cell anemia?
Valine is substituted for glutamic acid on the sixth position of the Beta chain
72
New cards
What test is used in sickle cell but cannot differentiate from disease and trait?
Sickle solubility
73
New cards
What is the confirmatory test for sickle cell?
Hemoglobin electrophoresis
74
New cards
What is seen on peripheral smear in hemoglobin C disease?
Hgb C crystals, target cells
75
New cards
What is increased in hemochromatosis?
Iron absorption
76
New cards
What anemia is found in mononucleosis?
Cold agglutinin
77
New cards
What percent of transferrin is bound to iron?
30%
78
New cards
How is intravascular distinguished from extravascular hemolysis?
Urine hemosiderin
79
New cards
What other tests are utilized in the detection of hemolytic anemia?
Bilirubin, haptoglobin, urine hemosiderin
80
New cards
What is the retic value for anemias?
increased in hemolytic anemias, decreased in nutritional deficiency until needs are met then increased, normal or decreased in aplastic anemia
81
New cards
Which of the anemias are life threatening?
Alpha thalassemia major
82
New cards
How can IDA and thalassemia be differentiated?
Hemoglobin electrophoresis
83
New cards
How can Hgb A with Hgb S be confirmed?
Hemoglobin electrophoresis using citrate agar
84
New cards
How can IDA and anemia of chronic disease be differentiated?
Ferritin & TIBC
85
New cards
What will the bone marrow of anemia indicate?
Erythroid hyperplasia 1:1
86
New cards
What is the purpose of the schilling test?
Detects malabsorption of B12 found in pernicious anemia
87
New cards
What is the breakdown product of hemoglobin?
Urobilinogen
88
New cards
What is a product of heme synthesis?
One of the porphyrins: protoporphyrin, uroporphyrin, or coproporphyrin
89
New cards
Which thalassemia is more serious?
Alpha thalassemia major
90
New cards
What microscopic power is used to see BM megakaryocytes?
10x
91
New cards
What do karryohexis and asynchrony indicate?
Defective DNA synthesis
92
New cards
Which chemistry test are increased in hemolytic anemia?
Bili & LD
93
New cards
Which group of anemias has the most polychromasia?
Hemolytic anemias
94
New cards
Ringed sideroblasts on an iron stain indicate what?
Sideroblastic anemia
95
New cards
In aplastic anemia, what is the bone marrow fat to cell ratio?
90:10
96
New cards
If the wrong type of blood is transfused, what type of hemolysis is found?
Intravascular
97
New cards
What is the M:E ratio for erythroid hyperplasia?
1:1
98
New cards
How is the M:E ratio calculated?
Myeloid cells divided by erythroid cells
99
New cards
What is a normal M:E ratio?
3:1
100
New cards
What is the M:E ratio in anemia?
1:1